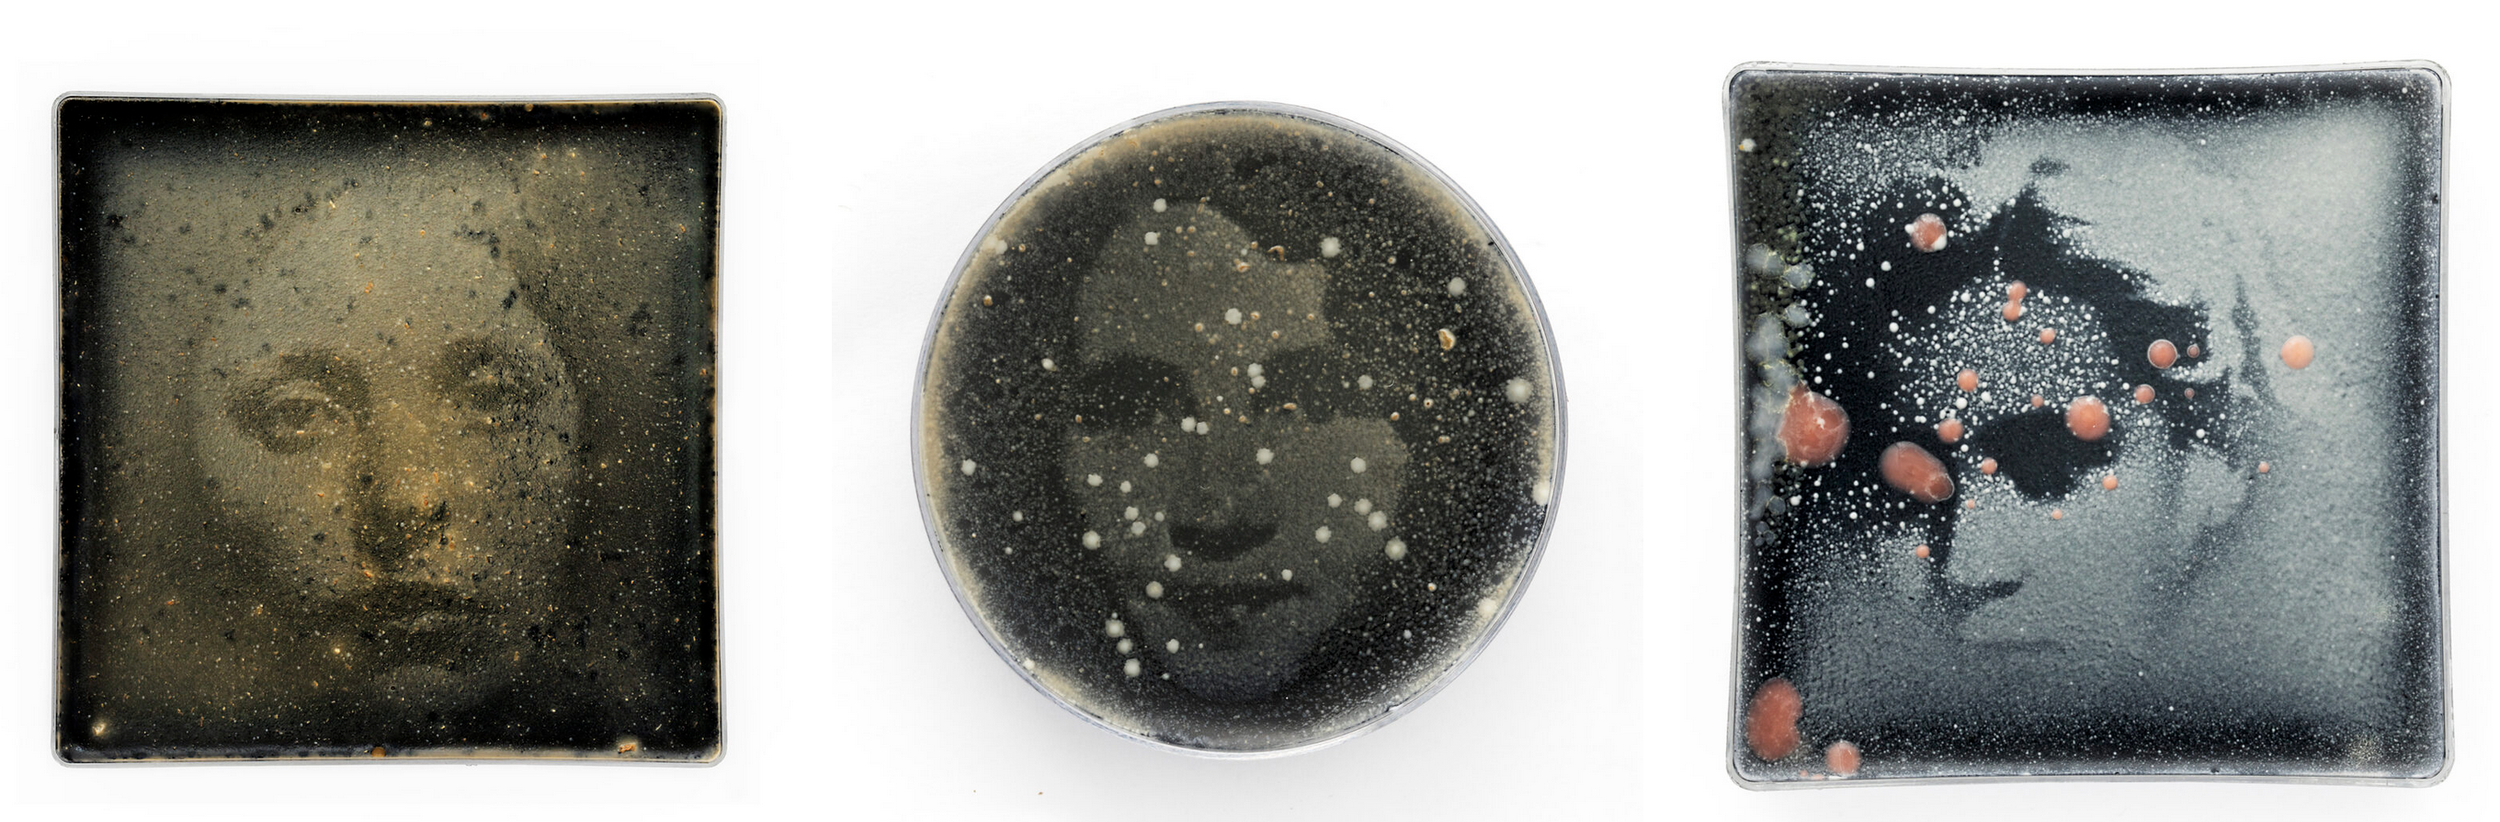

Johanna Rotko
Johanna Rotko introduces various microbes such as yeasts and moulds into photography material, and photographs them while living and interacting. Once she has finished her investigations she composts the materials in a bokashi compost system. This is the website specific to these works termed ‘yeastograms’: http://www.hiivagrammi.fi/portfolio2019/
Her general artist website is here:. https://www.johannarotko.com/